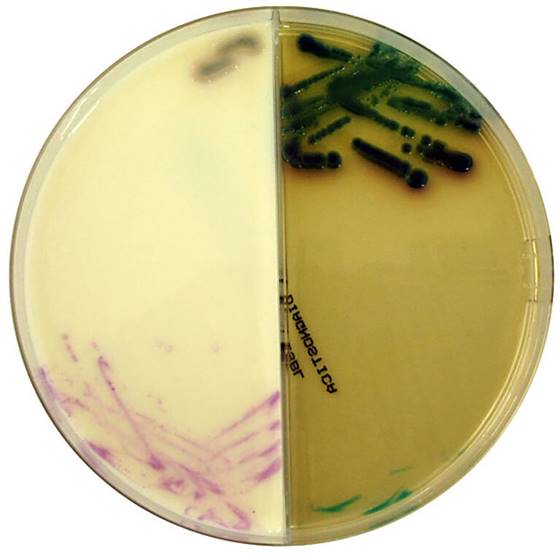

Über das Produkt
Chromogenes Medium für die Über-Nacht-Detektion von Extended-Spectrum Beta-Lactamase produzierenden gramnegativen Bakterien.
Produkte
Mikrobiologie
CHROMagar™ - Fertigplatten
CHROMagar ESBL/CHROMagar VRE geteilte Fertigplatten
CHROMagar ESBL/CHROMagar VRE geteilte Fertigplatten
Chromogenes Medium für die Über-Nacht-Detektion von Extended-Spectrum Beta-Lactamase produzierenden gramnegativen Bakterien.